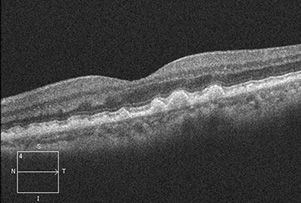
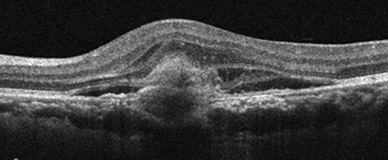

황반변성이란?
황반은 우리 눈에서 사물을 또렷하게 볼 수 있도록 도와주는 가장 중요한 부위입니다.
이 부위에 변화가 생기면 중심 시력이 떨어져 글씨가 흐려 보이거나 직선이 휘어져 보이는 증상이 나타나는데, 이를 황반변성이라고 합니다.


황반변성
정상안
왜 조기 진단이
중요한가요?
초기에는 뚜렷한 증상이 없어 노안으로 착각하기 쉽고, 한쪽 눈만 영향을 받을 경우 반대쪽 눈이 보완해 증상을 인지하기 어렵습니다. 정기적인 안과 검진을 통해 조기에 발견하는 것이 시력 보호의 핵심입니다.
황반변성의
종류
1. 건성 황반변성 (Dry AMD)
- 황반 주변에 노폐물(드루젠)이 쌓이면서 망막 세포가 천천히 손상됩니다.
- 진행이 느리지만 습성 황반변성으로 악화될 수 있어 주기적인 관찰이 필요합니다.

2. 습성 황반변성 (Wet AMD)
- 망막 아래에 비정상적인 신생혈관이 자라나면서 출혈, 부종, 시력 저하를 유발합니다.
- 치료 없이 방치하면 실명으로 진행될 수 있는 위험한 형태입니다.




주요 증상과
자가진단








황반변성 환자의 증상
사물이 휘어보인다. 중심시야가 어둡거나 보이지 않는다.
[ 암슬러 격자 자가검사 ]
- 약 30cm 거리에서 한쪽 눈을 가린 채로 중심의 점을 응시하고 격자를 관찰합니다.
- 선이 휘어 보이거나, 줄 간격이 다르거나, 중심의 점이 사라지거나 희미한 경우 즉시 안과 진료가 필요합니다.
치료 방법 및 관리
1. 건성 황반변성
- 특별한 치료법은 없지만, 진행을 늦추기 위해 눈 영양제 복용 및 정기적인 경과관찰이 필요합니다.
2. 습성 황반변성
습성 황반변성
습성 황반변성 유리체내 주사
유리체내 주사- 유리체내 주사 : 항혈관내피성장인자 항체를 눈 속에 주사하여 비정상적인 신생혈관을 억제함으로써 시력을 보존하거나 향상시킬 수 있습니다.
- 광역학치료: 광감작제(비쥬다인)를 혈관에 주입한 후 황반변성 부위에 특수 레이저를 조사하여 비정상적인 혈관만 선택적으로 치료합니다.
- 국소 레이저광응고술: 혈관 이상 부위를 직접 레이저로 응고시키는 방법으로 황반 중심 밖에 위치한 신생혈관의 치료에 선택적으로 이용합니다.
3. 치료 효과
- 항혈관내피성장인자 항체 주사로 70~80% 환자는 2년간 시력이 유지되었으며, 약 30%에서는 시력이 호전되는 효과를 보였습니다.
- 일반적으로 한 번의 주사로 치료가 끝나지 않으며, 시간 경과에 따라 약효가 떨어질 수 있어 정기적인 검사를 통해 적절하게 주사 치료를 받는 것이 시력 유지를 위해 중요합니다.
왜 모두다연세안과일까?
모두다연세안과는 황반변성 진단에 최적화된 정밀 진단 장비와 숙련된 의료진, 맞춤형 치료 전략, 지속적인 사후 관리를 통해 환자분의 삶의 질을 높입니다.
건성과 습성 형태에 따라 최적의 치료 계획을 세우고, 정기 검진과 신속한 치료 연계를 통해 시력 보호에 최선을 다합니다.










